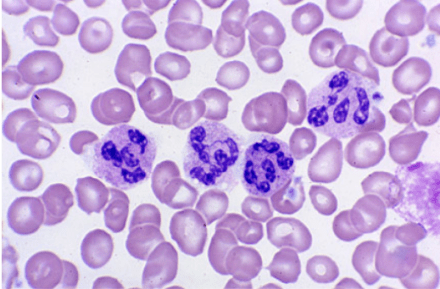
Hypersegmented Neutrophils

62-year-old male presents to primary provider’s office with a six-month history of fatigue and gait disturbance. He denies recent falls, weakness, pain, paralysis, or dizziness.
Medications
Lisinopril 10mg daily
Metformin 1000mg BID
Men’s multivitamin
Fish oil
Past Medical History
Diabetes Mellitus II
Hypertension
Gastric cancer
Past Surgical History
Cholecystectomy – 1997
Partial gastrectomy – 2004
Vitals
BP-128/79, HR-81, RR-14, O2-100%, Temp-98.9o
Physical Exam
General – WN/WD, NAD
Skin – scattered senile purpura, no petechiae
CV – RRR without M/G/R
Pulmonary – CTA bilaterally without adventitial breath sounds
Neurologic – A&Ox3, 5/5 strength throughout bilaterally, DTR 2+ and equal, FROM, vibratory sensation decreased in bilateral lower extremities
Laboratory Studies